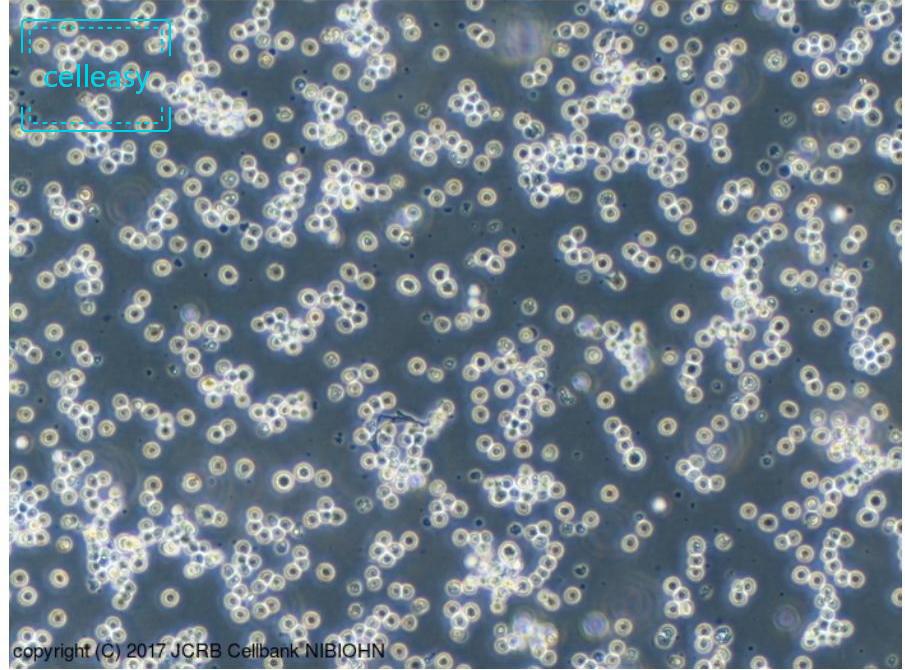
人Burkitt’s淋巴瘤细胞

描述
Daudi 细胞信息
| 细胞名称 | 人Burkitt’s淋巴瘤细胞 |
|---|---|
| 英文名 | Daudi |
| 货号 | CE0473 |
| 规格 | 1 × 10⁶ cells/T25 flask |
| 培养体系 | RPMI-1640 + 10% FBS ± 1% P/S |
| 别称 | DAUDI; NK-10A; NK-10a; GM03190; GM3190; GM17346 |
| 形态特征 | 淋巴母细胞样;圆形 |
| 生长特性 | 悬浮生长 |
| 培养条件 | 气相:95%空气 + 5%CO₂;温度:37℃ |
| 传代比例 | 1:2至1:5,每2-4天传代一次 |
| 组织来源 | 人外周血;B淋巴母细胞 |

评价
目前还没有评价